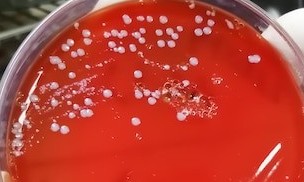

Esta es la revista en su versión más nueva, para números anteriores a enero de 2022 (volúmenes del 1 al 11) puede referirse al archivo
Aviso Importante
Enviar un artículo
Información
Visitantes
Síguenos en facebook

Todo el contenido de esta revista Abanico Veterinario, excepto dónde está identificado, es de acceso abierto no comercial y está bajo una Licencia Creative Commons (CC BY-NC 4.0) http://creativecommons.org/licenses/by-nc/4.0/deed.es
Tezontle 171 Pedregal de San Juan, Tepic Nayarit México C.P. 63164
Teléfono: (52-311) 1221626. URL: http://abanicoacademico.mx/revistasabanico/. E-Mail: abanicoveterinario@gmail.com
© Copyright - Sergio Martínez González
Abanico Veterinario. ISSN: e2448-6132